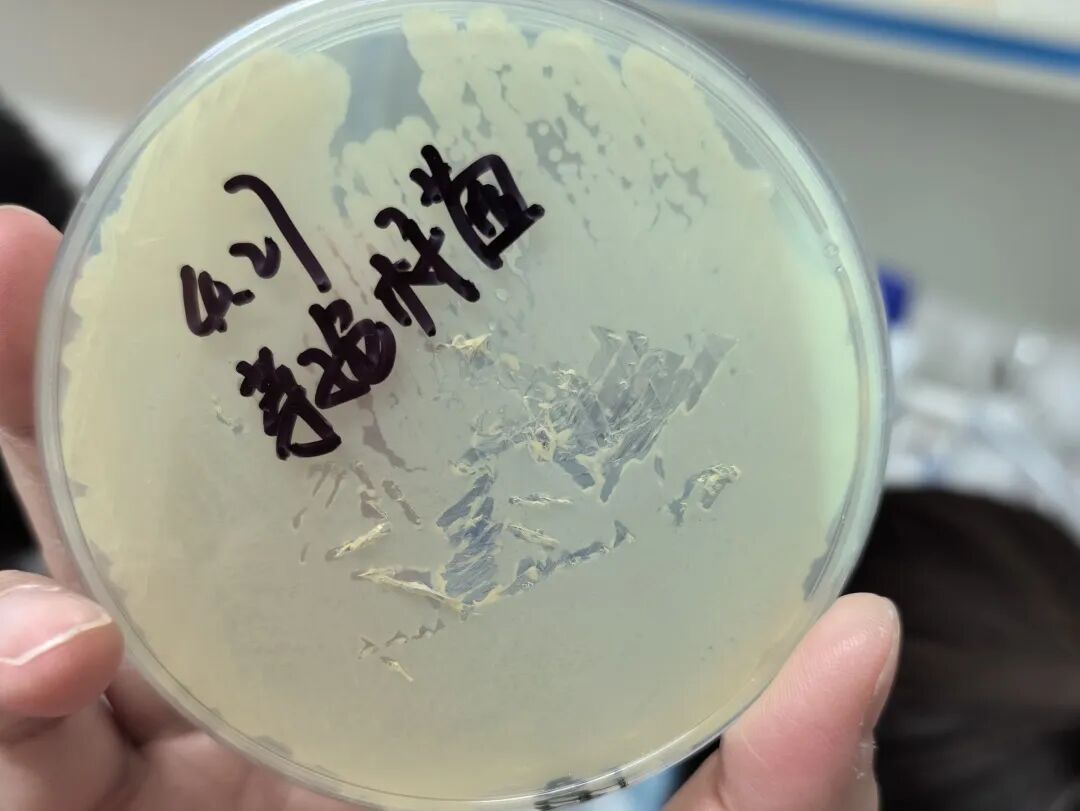
图片

行程概述
Day1:探秘微观世界
学习微生物基础,实操细菌结构观察与多种专业染色技术。
Day2:生命代谢探究
动手配制培养基,开展药敏实验,检测微生物生理生化特性。
Day3:基因密码解码
验证多种消毒灭菌效果,学习PCR原理并亲历体外扩增DNA。
生命是最精密的仪器
结构是功能的载体
没有结构,基因如何表达
没有基因,结构从何而来
当显微镜下浮现微观的细胞骨架
便是属于未来生命科学家的密钥
用观察解码生理机制
用实验重构基因法则
今天
前沿生物学正重塑我们对生命的认知
而驱动这一切的
正是对微观结构与基因序列的深度解构

3天时间青少年深入科学院实验室
解析细菌分裂的微观节律
看芽孢与鞭毛如何承载生存密码
制备培养基
让微生物在显微镜下展现生命脉动
扩增DNA
在微观尺度中触摸基因的实体
从革兰氏染色到PCR扩增
在微米级的视野间隙里
感受科学家探索生命本源的严密
我们相信
每个参与涂布、接种、扩增的少年
都将成为基因奥秘的破译人
此刻在实验台上记录的每一个数据
都在为生命科学的未来储备新生力量。









行程安排
DAY 1
微观探秘
细菌结构与染色实操

收获:通过理论结合实操,了解细菌基本组成与特殊结构,掌握染色实验原理和流程,完成菌悬液制备、染色观察等操作,提升动手及显微镜使用能力,培养严谨实验态度,深化理论与实践的联系。
上午:
✅ 微生物基础理论学习:系统讲解细菌的基本组成与特殊结构,解析芽孢、鞭毛染色的实验原理与标准化流程

✅ 实验样本制备:亲手制备芽孢杆菌、大肠杆菌菌悬液

✅ 芽孢染色全流程实操:完成制片 - 染色 - 脱色 - 复染 - 水洗 - 镜检全环节操作

下午:
✅ 鞭毛染色全流程实操:完成标准化染色与镜检观测
✅ 革兰氏染色实验:通过染色区分并观察革兰氏阴性、阳性细菌

✅ 核酸染色观测:自主配置试剂、制备生物样本与组织切片,染色观察口腔上皮细胞或植物细胞中的 DNA 与 RNA

DAY 2
生理生化
微生物特性与细胞观察

收获:学习微生物生理生化特性相关实验,掌握微生物培养、药敏检测、细胞观察等知识,完成培养基配制、细菌接种、细胞染色等实操,提升实验、动手及观察能力,培养严谨态度与科学思维,为后续学习奠定基础。
上午:
✅ 实验原理讲解:系统介绍培养基的种类与配制规范,解析药敏实验(抑菌圈法)的核心原理

✅ 固体培养基制备:亲手配制 LB 琼脂培养基,完成灭菌与倒平板全流程操作

✅ 药敏实验实操:将大肠杆菌涂布于平板,放置不同抗生素纸片并做好标记,完成实验体系搭建

✅ 细菌运动性检测培养基制备:配制半固体培养基,用于后续细菌运动性观测

下午:
✅ 细菌运动性检测:使用接种针穿刺接种大肠杆菌与芽孢杆菌于半固体培养基,培养后观察细菌沿穿刺线的扩散情况,判断细菌运动性

✅ 酵母菌呼吸实验:完成酵母菌呼吸实验操作,观察不同糖类对酵母菌呼吸速率的影响

✅ 植物细胞染色体观察:使用洋葱样本制作压片,完成植物细胞染色体与细胞分裂过程的显微观测


DAY 3
灭菌与基因
消毒评价与基因技术入门

收获:重点学习细菌消毒效果评价与DNA体外扩增知识。上午学习微生物消毒灭菌原理,配制培养基,用伊红美蓝检测水中大肠杆菌,学习PCR并完成大肠杆菌、霉菌接种;下午实操酒精、高压蒸汽、紫外线消毒灭菌,学习洗手液制作,提升实操能力,加深微生物知识理解与科研兴趣。
上午:
✅ 理论精讲:系统讲解微生物消毒与灭菌的常用方法、核心原理与适用场景

✅ 微生物检测实操:配置伊红美蓝微生物培养基,检测不同水样中的大肠杆菌含量

✅ 微生物接种操作:完成大肠杆菌与霉菌的标准化接种
✅ PCR 技术原理讲解与演示:系统解析基因扩增(PCR)的核心原理,完成实验演示

上午:
✅ 多模式消毒灭菌实操:分别通过酒精消毒、高压蒸汽灭菌、紫外线照射三种方式,完成接种微生物的杀灭处理,对比消毒灭菌效果

✅ 日用科普实操:学习并亲手完成洗手液的制备,理解消毒产品的作用原理

课标知识深度内化
全面覆盖初高中生物核心知识点,将细胞结构、微生物学、遗传物质、基因技术等课本内容转化为实操体验,打破纸上谈兵的学习壁垒,实现知识的深度理解与长效记忆。
核心实验技能系统掌握
熟练掌握光学显微镜使用、生物制片与染色、无菌操作、微生物培养、消毒灭菌等生命科学基础实验技能,建立标准化的实验操作规范,养成严谨认真的实验习惯。
科学思维与素养全面养成
通过完整的 “原理学习 - 方案设计 - 动手实操 - 结果观测 - 分析总结” 科学实验闭环,建立严谨的逻辑思维与探究式学习能力,培养求真务实的科学素养。
生命科学探索热情深度点燃
解码 “结构决定功能、基因掌控生命” 的生命底层逻辑,打破对生命科学的认知壁垒,守护孩子的好奇心,为未来的理科学习与科研兴趣埋下坚实的种子。
常见问题
参加研学需要额外准备实验服和实验器具吗?
不用额外准备!我们已提前为每位孩子配齐了专业实验服与全套实验器具,既免去了家长准备的麻烦,也能保证孩子实验操作的规范性与安全性,到场即可直接使用。
孩子操作实验时,安全防护能保障到位吗?
可以!我们设置了 3 重安全防护保障,全程筑牢安全防线:
装备防护:为每位孩子准备一次性手套、防护口罩与专用实验服,全程规范穿戴后方可参与实验操作;
实操指导:每 3-4 名孩子配备 1 名专业导师,手把手指导实验步骤,全程监督,杜绝违规操作;
环境保障:实验台面提前完成消毒,实验后统一指导孩子使用医用洗手液彻底清洁双手,避免实验残留。
孩子会接触到危险的细菌或病毒吗?
不会。实验样本均为非致病性微生物(如酵母菌、安全的乳酸菌等),不会导致人体感染,且所有实验样本均经过专业机构安全认证,从源头上杜绝生物安全风险。
还需要给孩子准备什么学习用品?
建议给孩子准备一个轻便的小本子和一支笔即可。




